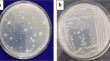
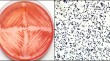

Latest research

New insights into radiolabelled siderophores for molecular imaging of bacterial infections
in npj Imaging







Functional Chitosan Films with Improved Physical-Mechanical Properties and Antibacterial Activity against Bacillus subtilis and Escherichia coli
in Microbiology